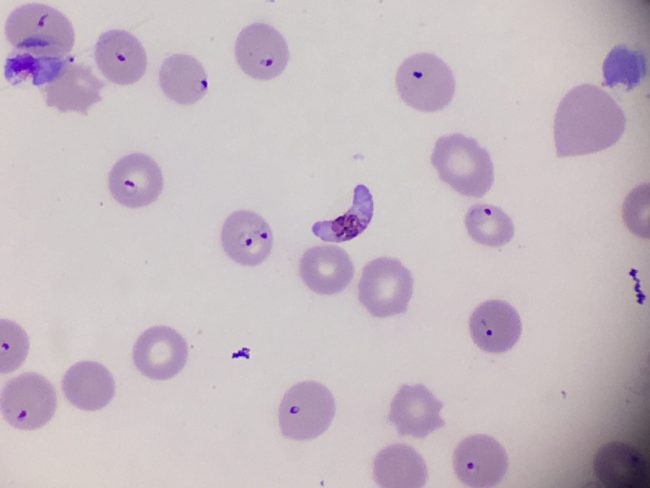

Campanha de Vacinação contra a Influenza no INI
Campanha de Vacinação contra a Influenza no INI Juana Portugal A Vice Direção de Qualidade e Informação comunica que a Campanha de Vacinação contra a Influenza ocorrerá nos dias 18 e 19 de maio. No dia 18 a Campanha foi realizada no Consultório 06 do Ambulatório e hoje, dia 19, terá continuidade no 2º Andar…